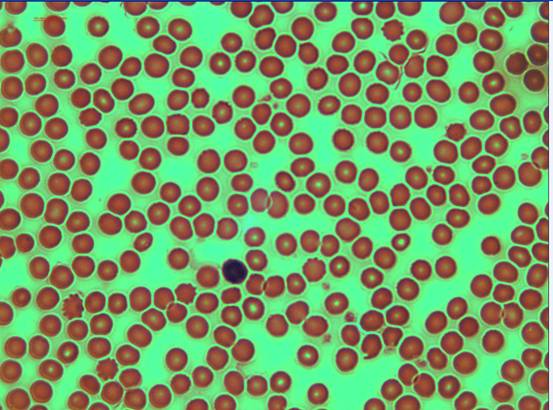

ABOUT STORE
Hanning Trading is an international buying house and China buying agent. We assist clients to source for products directly from the manufacturers or suppliers or from clients’ instructions to purchase the products that they saw on the e-Shopping / e-Commerce sites as are listed on our website.
Email: hanningtrading@163.com